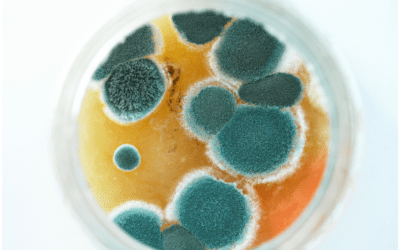
Jak se zbavit vlhkosti ve zdi

Deratizace Frýdlant Hledáte spolehlivou službu deratizace Frýdlant? Zajišťujeme profesionální zásahy proti potkanům, myším, štěnicím, blechám, švábům, vosám i dalším škůdcům v bytech, rodinných domech, firmách, restauracích, skladech i veřejných...
Užitečné články
Deratizace FM
Deratizace FM Hledáte spolehlivou službu deratizace FM? Zkratka FM nejčastěji označuje město Frýdek-Místek, kde zajišťujeme profesionální zásahy proti potkanům, myším, štěnicím, blechám, švábům, vosám i dalším škůdcům. Pomáháme domácnostem, firmám, restauracím,...
Deratizace Bohumín
Deratizace Bohumín Hledáte spolehlivou službu deratizace Bohumín? Zajišťujeme profesionální zásahy proti potkanům, myším, blechám, štěnicím, vosám, švábům i dalším škůdcům v bytech, rodinných domech, provozovnách, skladech i firemních objektech. Rychlý...
Deratizace blech Ostrava
Deratizace blech Ostrava Objevily se u vás blechy v bytě, rodinném domě nebo provozovně? Deratizace blech Ostrava je nejrychlejší cesta k účinnému odstranění tohoto nepříjemného hmyzu. Blechy se velmi rychle množí, ukrývají se v kobercích,...
Jak odstranit plíseň ze zdi
Jak odstranit plíseň ze zdi Jak odstranit plíseň ze zdi je častý dotaz majitelů bytů i domů, zejména v místnostech s vyšší vlhkostí nebo nedostatečným větráním. Napadené stěny nejsou pouze estetický problém, ale mohou ovlivnit kvalitu vzduchu...
Jak se zbavit plísně na zdi
Jak se zbavit plísně na zdi Jak se zbavit plísně na zdi je častý dotaz majitelů bytů i domů, zejména v zimních měsících nebo v místnostech s vyšší vlhkostí. Plíseň na stěnách není jen estetický problém, ale může negativně ovlivnit kvalitu vzduchu...
Zábrany proti ptactvu
Zábrany proti ptactvu Zábrany proti ptactvu jsou účinným řešením, jak ochránit balkony, parapety, střechy, římsy a další části budov před holuby a jiným ptactvem. Pomáhají zabránit posedávání, hnízdění i znečištění trusem. Správně zvolený systém ochrany...
Ochranný pás proti ptákům
Ochranný pás proti ptákům Ochranný pás proti ptákům je praktické řešení, které pomáhá zabránit dosedání holubů a dalšího ptactva na parapety, římsy, zábradlí nebo jiné úzké plochy. Používá se především tam, kde je potřeba nenápadná a dlouhodobá ochrana...
Ptačí trus
Ptačí trus Ptačí trus je častý problém na balkonech, parapetech, fasádách, střechách i veřejných prostorech. Kromě estetického znečištění může představovat také zdravotní riziko a dlouhodobě poškozovat povrchy budov. Nejčastěji se s ním setkáváme u...
Ochranná síť proti ptactvu
Ochranná síť proti ptactvu Ochranná síť proti ptactvu je účinné a dlouhodobé řešení, které chrání balkony, lodžie, fasády, světlíky i další prostory před holuby a jiným ptactvem. Správně instalovaný systém je nenápadný, bezpečný a nepoškozuje...
Sítě proti ptákům
Sítě proti ptákům Sítě proti ptákům patří mezi nejúčinnější způsoby ochrany balkonů, fasád a střech před holuby i jiným ptactvem. Zabraňují hnízdění, posedávání a znečištění trusem. Správně instalovaná ochranná síť je dlouhodobým a humánním řešením...
Ochrana proti ptactvu
Ochrana proti ptactvu Ochrana proti ptactvu je důležitá pro majitele domů, bytových domů, firemních objektů i veřejných budov. Holubi a další ptáci mohou způsobovat znečištění trusem, poškození fasád, zanášení okapů a hygienické problémy. Správně...
Hroty proti ptactvu
Hroty proti ptactvu Hroty proti ptactvu patří mezi nejúčinnější způsoby ochrany budov před dosedáním holubů a dalšího ptactva. Používají se na parapety, římsy, střechy, reklamní poutače i další místa, kde ptáci způsobují znečištění nebo škody. Správně...
Hubení včel
Hubení včel Hubení včel je vyhledávaný pojem zejména ve chvíli, kdy se roj nebo včelstvo usadí v blízkosti domu, půdy, střechy nebo komína. Ve skutečnosti jsou včely velmi užitečný hmyz a ve většině případů se neprovádí jejich likvidace, ale bezpečné...
Likvidace včel
Likvidace včel Likvidace včel je téma, které lidé řeší ve chvíli, kdy se roj nebo včelstvo usadí v blízkosti domu, komína, střechy nebo půdy. Včely jsou užitečný a chráněný hmyz, proto by měl být zásah vždy šetrný a odborný. Ve většině případů se...
Velká černá včela
Velká černá včela Velká černá včela je označení, které lidé často používají pro nápadný druh hmyzu s tmavým tělem a hlasitým letem. Ve většině případů se jedná o drvodělku fialovou, která patří mezi samotářské včely. Přestože může působit hrozivě,...
Jak dlouho žije včela
Jak dlouho žije včela Jak dlouho žije včela je častá otázka lidí, kteří se zajímají o přírodu, včelařství nebo mají v okolí domu včelí úl. Délka života včely závisí na jejím druhu, roli v úlu a ročním období. Jinou životnost má dělnice, jinou...
HACCP certifikát
HACCP certifikát HACCP certifikát je dokument, který potvrzuje, že provoz splňuje požadavky na bezpečnost potravin podle systému HACCP. Tento systém pomáhá předcházet rizikům při manipulaci s potravinami. V praxi se často setkáte také s pojmem haccp...
Co je to HACCP
Co je to HACCP Co je to HACCP je otázka, kterou si kladou provozovatelé restaurací, jídelen i potravinářských provozů. Mnoho lidí hledá také variantu co je haccp, přičemž jde o systém zaměřený na zajištění bezpečnosti potravin a prevenci zdravotních...
Jak se zbavit molů v bytě
Jak se zbavit molů v bytě Jak se zbavit molů v bytě je častý problém, který se týká jak kuchyně, tak šatních skříní. Tito škůdci se rychle množí a mohou poškodit potraviny i oblečení. Pokud přemýšlíte, co na moli skutečně funguje, je důležité zvolit...
Likvidace molů
Likvidace molů Likvidace molů je důležitým krokem při ochraně potravin i oblečení v domácnosti. Tito škůdci se rychle množí a dokážou napáchat značné škody, zejména ve spíži a šatních skříních. Pokud problém neřešíte včas, může být následná...
Jak vyhubit potravinové moly
Jak vyhubit potravinové moly Jak vyhubit potravinové moly je problém, který trápí mnoho domácností. Tito škůdci napadají mouku, rýži, těstoviny, ořechy i další suché potraviny a dokážou se velmi rychle rozmnožit. Pokud se objeví ve spíži, je nutné jednat...
Jak se zbavit moučných molů
Jak se zbavit moučných molů Jak se zbavit moučných molů je častý problém v domácnostech, kde se skladují suché potraviny. Tito škůdci napadají mouku, rýži, těstoviny, ořechy i další zásoby a dokážou se velmi rychle rozšířit. Pokud jejich výskyt neřešíte...
Jak se zbavit šatních molů
Jak se zbavit šatních molů Jak se zbavit šatních molů je častý problém v domácnostech, kde dochází k poškození oblečení a textilií. Tito škůdci se živí přírodními vlákny, jako je vlna, bavlna nebo kožešiny, a dokážou napáchat značné škody. Pokud...
Jak vypadá mol
Jak vypadá mol Jak vypadá mol je častá otázka při prvním výskytu tohoto škůdce v domácnosti. Moli jsou drobný létající hmyz, který si často lidé pletou s malými motýly. Rozpoznání molů je důležité pro včasné řešení problému a zabránění jejich...
Moli
Moli Moli patří mezi nejčastější škůdce v domácnosti. Objevují se ve spíži, šatníku i dalších částech bytu, kde nacházejí potravu a vhodné podmínky pro rozmnožování. Přestože dospělí jedinci nejsou příliš nebezpeční, jejich larvy dokážou napáchat značné...
Larvy molů
Larvy molů Larvy molů jsou nejškodlivější fází života těchto nepříjemných škůdců. Zatímco dospělí jedinci většinou pouze létají, právě larvy způsobují škody na potravinách, oblečení i dalších materiálech. Pokud se ve vaší domácnosti objeví, je důležité jednat...
Jak chytit myš v bytě
Jak chytit myš v bytě Jak chytit myš v bytě je problém, který může potkat každého. Myši se dokážou dostat i do panelových bytů a rychle si vytvoří úkryt v kuchyni, komoře nebo za nábytkem. Je důležité jednat co nejdříve, protože se rychle množí...
Jak na myši v domě
Jak na myši v domě Jak na myši v domě je častý problém, který řeší mnoho domácností. Myši hledají teplo, potravu a úkryt, a proto se snadno dostanou do interiéru, kde se rychle množí. Pokud zaznamenáte jejich přítomnost, je důležité jednat co nejdříve...
Jak vypudit myši
Jak vypudit myši Jak vypudit myši je otázka, kterou řeší mnoho lidí při prvním výskytu hlodavců v domácnosti. Myši hledají teplo, potravu a úkryt, a proto se snadno dostanou do domů i bytů. Pokud přemýšlíte, co na myši opravdu funguje, je důležité...
Jak se zbavit myší v bytě
Jak se zbavit myší v bytě Jak se zbavit myší v bytě je problém, který může potkat i obyvatele panelových domů. Myši se dokážou dostat přes stoupačky, sklepy nebo malé škvíry a rychle si vytvoří úkryt. Je důležité jednat co nejdříve, protože hlodavci se...
Jak se zbavit myší ve stropě
Jak se zbavit myší ve stropě Jak se zbavit myší ve stropě je problém, který dokáže výrazně narušit klid v domácnosti. Škrábání, dupání nebo pískání ve stropě bývá nejčastěji slyšet v noci, kdy jsou myši nejaktivnější. Pokud tento problém neřešíte včas, může...
Jak se zbavit myší v domě
Jak se zbavit myší v domě Jak se zbavit myší v domě je problém, který řeší mnoho domácností zejména v chladnějších měsících. Myši hledají teplo, potravu a bezpečný úkryt, a proto se snadno dostanou do interiéru. Pokud se hlodavci usadí, je důležité...
Jak se zbavit myší na půdě
Jak se zbavit myší na půdě Jak se zbavit myší na půdě je častý problém majitelů rodinných domů. Půda představuje ideální prostředí – je klidná, teplá a nabízí dostatek úkrytů. Pokud se zde myši usadí, mohou způsobit škody na izolaci, elektroinstalaci...
Ochrana proti myším
Ochrana proti myším Ochrana proti myším je důležitá pro každou domácnost i firmu. Myši se dokážou dostat i velmi malými otvory a rychle se přizpůsobí prostředí, kde mají dostatek potravy a úkryt. Pokud chcete účinnou ochrana proti myším, je potřeba...
Jak odpudit myši
Jak odpudit myši Jak odpudit myši je častá otázka v domácnostech, kde se objevují hlodavci. Myši hledají teplo, potravu a bezpečný úkryt, a proto se snadno dostanou do bytů i rodinných domů. Pokud řešíte, jak odpudit mysi, je důležité zaměřit se...
Co pomáhá proti myším
Co pomáhá proti myším Co pomáhá proti myším je otázka, kterou řeší mnoho domácností zejména v chladnějších měsících. Myši hledají teplo a potravu, a proto se snadno dostanou do domů i bytů. Pokud chcete účinně zasáhnout proti myším, je důležité...
Chytání myší
Chytání myší Chytání myší je častým řešením při výskytu hlodavců v domácnosti. Myši se dokážou rychle přizpůsobit a ukrývat se v těžko dostupných místech, proto je důležité zvolit správný postup. Pokud nevíte, na co chytit myš, existuje několik...
Jak zlikvidovat myši v domě
Jak zlikvidovat myši v domě Jak zlikvidovat myši v domě je otázka, kterou řeší mnoho domácností zejména v chladnějších měsících. Myši hledají teplo a potravu, a proto se snadno dostanou do domů, kde si vytvoří úkryt. Pokud problém neřešíte včas,...
Myš doma
Myši doma Myši doma jsou problém, který může potkat každou domácnost. Tito drobní hlodavci se dokážou dostat i velmi malými otvory a rychle si vytvoří úkryt v bytě nebo domě. Pokud zaznamenáte jejich přítomnost, je důležité jednat co nejdříve, protože...
Myš ve zdi
Myš ve zdi Myš ve zdi je problém, který dokáže být velmi nepříjemný. Typickým znakem je škrábání, pohyb nebo pískání ve stěnách, nejčastěji v noci. Pokud tento problém ignorujete, může se situace rychle zhoršit, protože myši se velmi rychle množí. Přítomnost...
Myš v bytě
Myš v bytě Myš v bytě je nepříjemný problém, který dokáže zaskočit každého. Tito drobní hlodavci se dokážou dostat i do panelových bytů a rychle si zde vytvořit úkryt. Pokud se objeví myši v bytě, je důležité jednat co nejdříve. Přítomnost hlodavců...
Deratizace myší cena
Deratizace myší cena Deratizace myší cena patří mezi nejčastější dotazy při výskytu hlodavců v domácnosti nebo firmě. Cena zásahu se může lišit podle rozsahu problému, typu objektu i použité metody. Je důležité si uvědomit, že každý případ je individuální...
Trus myši
Trus myši Trus myši je jedním z nejčastějších znaků, že se ve vaší domácnosti nachází hlodavci. Malé tmavé bobky se mohou objevit v kuchyni, spíži, na půdě nebo ve sklepě. Pokud je objevíte, je důležité jednat rychle, protože myši se velmi rychle množí....
Hubení myší
Hubení myší Hubení myší patří mezi časté problémy v domácnostech i firmách. Myši se rychle množí a jejich výskyt může způsobit škody i zdravotní komplikace. Pokud řešíte hubeni mysi, je důležité jednat co nejdříve. Proč se myši objevují v domě...
Jak se zbavit myšího zápachu
Jak se zbavit myšího zápachu Jak se zbavit myšího zápachu je častý problém v domácnostech, kde se vyskytují nebo vyskytovaly myši. Zápach vzniká především z moči, trusu nebo uhynulých jedinců a může být velmi nepříjemný a dlouhodobý. Pokud zápach...
Myš domácí mazlíček
Myš domácí mazlíček Myš domácí mazlíček je oblíbenou volbou pro lidi, kteří hledají malé, aktivní a poměrně nenáročné zvíře do bytu. Domestikované myši jsou zvědavé, čilé a při správné péči mohou být velmi zajímavými společníky. Pokud zvažujete, zda je myš...
Jak na pavouky
Jak na pavouky Jak na pavouky je otázka, kterou řeší mnoho domácností zejména v období podzimu nebo ve starších objektech. Přestože většina pavouků není nebezpečná, jejich přítomnost může být nepříjemná. Pokud hledáte účinné řešení proti pavoukům, je důležité...
Jak se zbavit pavouků
Jak se zbavit pavouků Jak se zbavit pavouků je otázka, kterou řeší mnoho lidí zejména na podzim nebo ve starších domech. Pavouci sice nejsou většinou nebezpeční, ale jejich přítomnost v interiéru je pro mnoho lidí nepříjemná. Dobrou zprávou je, že existuje...
Pavoučí kousnutí
Pavoučí kousnutí Pavoučí kousnutí je téma, které řeší mnoho lidí ve chvíli, kdy se na kůži objeví zarudnutí, otok nebo svědivý pupínek. Přestože většina pavouků v domácnosti není pro člověka nebezpečná, jejich kousnutí může být nepříjemné a vyvolat obavy....
Deratizace pavoků
Deratizace pavouků Deratizace pavouků je častý požadavek u domácností i firem, kde se pavouci objevují ve větším množství. Přestože pavouci nejsou typickými hlodavci, termín deratizace pavouků se běžně používá pro označení jejich profesionální likvidace....
Hubení pavouků
Hubení pavouků Hubení pavouků řeší mnoho domácností, kde se pavouci objevují opakovaně nebo ve větším množství. Přestože většina pavouků není nebezpečná, jejich přítomnost může být nepříjemná a pro některé lidi i stresující. Pokud se pavouci...
Likvidace pavouků
Likvidace pavouků Likvidace pavouků je častým řešením v domácnostech, kde se pavouci objevují opakovaně nebo ve větším množství. Přestože většina pavouků není nebezpečná, jejich přítomnost může být nepříjemná a pro mnoho lidí i stresující. Pavouci se...
Co odpuzuje pavouky
Co odpuzuje pavouky Co odpuzuje pavouky je častá otázka všech, kteří se potýkají s jejich výskytem v bytě nebo domě. Přestože většina pavouků není nebezpečná, jejich přítomnost bývá nepříjemná, zejména pokud se objevují opakovaně. Dobrou zprávou je, že...
Pavouci druhy
Pavouci druhy Pavouci druhy patří mezi častá témata, zejména pokud se pavouci objevují v domácnosti nebo na fasádě domu. V České republice žije několik stovek druhů pavouků, ale jen malé množství z nich se běžně vyskytuje v blízkosti člověka....
Pavouk doma
Pavouk doma Pavouk doma je běžný jev, se kterým se setká téměř každý. Přestože většina pavouků není nebezpečná, jejich přítomnost může být pro mnoho lidí nepříjemná. Často se objevují v rozích místností, sklepech nebo kolem oken. Mnoho lidí řeší problém...
Ploštice hubení
Ploštice hubení Ploštice hubení je častým tématem v domácnostech, kde se objevují svědivé štípance, neklidný spánek nebo podezřelý hmyz v okolí postele. Ploštice domácí patří mezi velmi nepříjemné škůdce, protože se živí lidskou krví, ukrývají se ve...
Kousnutí od ploštice
Kousnutí od ploštice Kousnutí od ploštice je jedním z nejčastějších příznaků výskytu tohoto nepříjemného škůdce v domácnosti. Ploštice domácí se živí lidskou krví a napadají člověka především v noci během spánku. Mnoho lidí si kousnutí plete...
Ploštice postelní
Ploštice postelní Ploštice postelní (často označovaná jako štěnice domácí) patří mezi nejnepříjemnější škůdce v domácnosti. Tento drobný hmyz se živí lidskou krví a ukrývá se především v blízkosti postele, kde má snadný přístup ke své potravě. Její...
Ploštice v bytě
Ploštice v bytě (štěnice) Ploštice v bytě patří mezi nejčastější a zároveň nejnepříjemnější problémy v domácnosti. Tento drobný hmyz se živí lidskou krví a ukrývá se v blízkosti míst, kde spíme. Výskyt ploštic může způsobit nejen nepříjemné...
Štípanec od ploštice (štěnice)
Štípanec od ploštice Štípanec od ploštice bývá často prvním varováním, že se v domácnosti objevil nepříjemný škůdce. Ve skutečnosti se však nejedná o ploštice, ale o Štěnice domácí, které člověka koušou během spánku a živí se jeho krví. Lidé si...
Jak vypadají ploštice
Jak vypadají ploštice Jak vypadají ploštice je častá otázka lidí, kteří doma objevili drobný hmyz, zaznamenali štípance po spánku nebo mají podezření na výskyt štěnic. Ploštice domácí patří mezi nepříjemné škůdce, protože se živí krví a ukrývají se...
Ploštice domácí
Ploštice domácí Ploštice domácí patří mezi nepříjemné škůdce, kteří se mohou objevit v bytech i rodinných domech. Ve skutečnosti se však nejedná o ploštice, ale o Štěnice domácí, které se živí krví člověka a způsobují svědivé kožní reakce. Tento drobný hmyz je aktivní...
Deratizér na kuny
Deratizér na kuny Deratizér na kuny je odborník, který se zabývá řešením výskytu kuny v domě, na půdě nebo ve střeše. Kuna patří mezi chráněné živočichy, proto je nutné postupovat šetrně a legálně – nejčastěji formou odchytu nebo vyhnání. Pokud se kuna...
Jak odpudit kuny
Jak odpudit kuny Jak odpudit kuny je častá otázka majitelů domů, kteří se potýkají s tímto nezvaným návštěvníkem. Kuna si ráda vybírá půdy, střechy nebo jiné klidné prostory, kde nachází ideální podmínky pro život. Na rozdíl od jiných škůdců není cílem kunu...
Kuna jak se jí zbavit
Kuna jak se jí zbavit Kuna jak se zbavit je častá otázka majitelů domů, kteří se potýkají s tímto nezvaným návštěvníkem. Kuna si ráda vybírá půdy, střechy nebo dutiny v domě, kde nachází ideální podmínky pro život. Její přítomnost může způsobovat hluk,...
Kuna v domě
Kuna v domě Kuna v domě je nepříjemný problém, se kterým se setkává stále více majitelů rodinných domů. Tento noční živočich si často vybírá půdy, střechy nebo dutiny ve stavbě, kde nachází ideální podmínky pro život. Její přítomnost se projevuje nejen hlukem,...
Jak se zbavit kuny ve střeše
Jak se zbavit kuny ve střeše Jak se zbavit kuny ve střeše je častý problém majitelů rodinných domů. Kuna si velmi ráda vybírá střechy a podkroví, kde má ideální podmínky – klid, teplo a bezpečí. Její přítomnost však může způsobit hluk, zápach...
Hubení kun
Hubení kun Hubení kun je téma, které řeší mnoho majitelů rodinných domů. Kuna se často usazuje na půdách a v podkroví, kde nachází ideální podmínky pro život. Její přítomnost však přináší hluk, zápach i škody na majetku. Je důležité vědět, že kuna je...
Odchyt kuny
Odchyt kuny Odchyt kuny je nejbezpečnější způsob, jak řešit výskyt tohoto zvířete v domě nebo na půdě. Kuna si často vybírá podkroví jako své útočiště, kde může způsobit hluk i škody na majetku. V praxi se místo likvidace využívá šetrné řešení, protože...
Likvidace kuny
Likvidace kuny Likvidace kuny je častým problémem majitelů rodinných domů. Kuna si velmi ráda vybírá půdy a podkroví jako své útočiště, kde má klid, teplo a dostatek prostoru. Její přítomnost však může způsobit značné škody a nepříjemnosti. Vzhledem...
Kuna trus
Kuna trus Kuna trus je jedním z nejčastějších znaků, podle kterého poznáte přítomnost kuny v domě, na půdě nebo v okolí zahrady. Pokud objevíte podezřelé výkaly, je důležité správně určit, zda skutečně patří kuně. Mnoho lidí si klade otázku jak vypadá...
Kuna na půdě
Kuna na půdě Kuna na půdě je častý problém zejména u rodinných domů. Tento šikovný predátor si rád hledá úkryt v podkroví, kde má klid a teplo. Bohužel může způsobit značné škody na izolaci, elektroinstalaci i konstrukci střechy. Lidé často hledají...
Jak vyhubit krysy
Jak vyhubit krysy Jak vyhubit krysy je otázka, kterou je potřeba řešit rychle a efektivně. Krysy patří mezi velmi nebezpečné hlodavce, kteří přenášejí nemoci, ničí majetek a dokážou se během krátké doby přemnožit. Pokud se krysy objeví v domě, sklepě...
Likvidace krys
Likvidace krys Likvidace krys je nezbytná při výskytu těchto nebezpečných hlodavců v domácnosti, sklepě nebo na zahradě. Krysy se rychle množí, způsobují škody na majetku a představují významné hygienické riziko. Včasná a správně provedená likvidace je...
Hubení krys
Hubení krys Hubení krys je důležité řešit co nejdříve po zjištění jejich výskytu. Krysy patří mezi nebezpečné hlodavce, kteří mohou přenášet nemoci, poškozovat majetek a rychle se množit. Výskyt krys v domě, sklepě nebo na zahradě není radno podceňovat. Bez...
Jak na krysy
Jak na krysy Jak na krysy je otázka, kterou řeší mnoho lidí při výskytu těchto nebezpečných hlodavců. Krysy (často zaměňované s potkany) se rychle množí, způsobují škody na majetku a mohou přenášet nemoci. Pokud se krysy objeví v domě, sklepě nebo na...
Jak chytit krysu
Jak chytit krysu Jak chytit krysu je problém, který je potřeba řešit rychle a efektivně. Krysy patří mezi velmi inteligentní hlodavce, kteří se dokážou vyhýbat nebezpečí a rychle se množí. Proto je důležité zvolit správnou strategii odchytu. Výskyt krysy...
Jak se zbavit krysy
Jak se zbavit krysy Jak se zbavit krysy je otázka, kterou řeší mnoho domácností i firem. Krysy (často zaměňované s potkany) patří mezi nejnebezpečnější hlodavce, protože mohou přenášet nemoci, ničit majetek a rychle se množit. Pokud se krysa objeví...
Pisivka likvidace
Pisivka likvidace Pisivka likvidace je časté téma zejména v domácnostech se zvýšenou vlhkostí. Pisivky jsou drobný hmyz, který se živí plísněmi a organickými zbytky, a proto se často objevují na vlhkých zdech, v knihách nebo ve spárách nábytku. Ve...
Rybenky v bytě
Rybenky v bytě Rybenky v bytě patří mezi časté škůdce, se kterými se lidé setkávají zejména v koupelnách, na toaletách nebo v kuchyni. Tento drobný hmyz je aktivní hlavně v noci a vyhledává vlhké a teplé prostředí. I když rybenky...
Hmyz v domácnosti obrázky
Hmyz v domácnosti obrázky Hmyz v domácnosti obrázky je časté vyhledávání lidí, kteří doma objevili neznámého škůdce. Obrázky pomáhají rychle porovnat vzhled hmyzu a určit, o jaký druh se jedná. Pokud se u vás objeví neznámý hmyz, právě hmyz...
Hmyz v domácnosti druhy
Hmyz v domácnosti druhy Hmyz v domácnosti druhy je problém, se kterým se setkává mnoho domácností. Výskyt hmyzu může být nepříjemný, ale i nebezpečný z hlediska hygieny. Proto je důležité jednotlivé druhy správně rozpoznat a zvolit vhodné řešení....
Myšice polní
Myšice polní Myšice polní je drobný hlodavec, který se běžně vyskytuje v přírodě, ale často proniká i do blízkosti lidských obydlí. Nejčastěji ji najdeme na polích, zahradách nebo ve skladech, kde může způsobovat značné škody. V chladnějších měsících se...
Desinfekce
Co je desinfekce a proč je to problém Desinfekce je klíčový proces, který zajišťuje odstranění škodlivých mikroorganismů z prostředí. Jedná se především o bakterie, viry, plísně a další patogeny, které mohou ohrozit zdraví člověka. V běžném životě si často myslíme, že...
Systém HACCP
Systém HACCP Systém HACCP je základní nástroj pro zajištění bezpečnosti potravin. Používá se v gastronomii i potravinářství a jeho cílem je předcházet zdravotním rizikům spojeným s konzumací potravin. Tento přístup vychází z analýzy rizik...
HACCP potraviny
HACCP potraviny HACCP potraviny je pojem, který označuje systém kontroly bezpečnosti potravin. HACCP pomáhá identifikovat rizika při výrobě, skladování a manipulaci s potravinami a nastavuje pravidla, která těmto rizikům předcházejí. Každý provoz, který...
HACCP vypracování
HACCP vypracování HACCP vypracování je proces vytvoření systému, který zajišťuje bezpečnost potravin v provozu. Tento systém je povinný pro všechny podniky, které manipulují s potravinami – od restaurací až po výrobny. Správně zpracovaný HACCP plán...
HACCP zkratka
HACCP zkratka HACCP zkratka je často vyhledávaný pojem v oblasti gastronomie a potravinářství. Pokud vás zajímá, co přesně tato zkratka znamená, jedná se o systém řízení bezpečnosti potravin, který pomáhá předcházet zdravotním rizikům. Zkratka HACCP...
Svědění kůže v posteli
Svědění kůže v posteli Svědění kůže v posteli je nepříjemný problém, který může mít více příčin. Nejčastěji se objevuje v noci nebo ráno po probuzení a může výrazně narušit kvalitu spánku. Pokud se potíže opakují, je důležité zjistit jejich původ –...
Štípance na nohou
Štípance na nohou Štípance na nohou patří mezi časté projevy napadení hmyzem. Nejčastěji se objevují v oblasti kotníků a lýtek, kde je kůže snadno dostupná. Tyto štípance mohou být nepříjemné, svědivé a někdy i bolestivé. Pokud se objevují...
Malé štípance na těle
Malé štípance na těle Malé štípance na těle mohou být nepříjemným signálem přítomnosti hmyzu v domácnosti. Nejčastěji se objevují během noci a lidé si jich všimnou až ráno po probuzení. Pokud se objeví opakovaně, je vhodné zjistit jejich příčinu....
Dva štípance vedle sebe
Dva štípance vedle sebe Dva štípance vedle sebe jsou poměrně typickým projevem napadení hmyzem. Tento vzor se často objevuje zejména u štěnic, ale může být způsoben i jinými škůdci. Pokud se štípance opakují nebo se objevují pravidelně, je důležité zjistit...
Bílý červ v domácnosti
Bílý červ v domácnosti Bílý červ v domácnosti je označení, které lidé často používají pro různé larvy hmyzu. Ve skutečnosti se většinou nejedná o červy, ale o vývojová stádia much, brouků nebo potravinových škůdců. Výskyt těchto larev může signalizovat...
Černé housenky v bytě
Černé housenky v bytě Černé housenky v bytě jsou nepříjemným problémem, který může signalizovat výskyt škůdců. Ve většině případů nejde o klasické housenky motýlů, ale o larvy hmyzu, například potravinových molů nebo jiných druhů škůdců. Pokud se černé...
Ochrana proti vlaštovkám
Ochrana proti vlaštovkám Ochrana proti vlaštovkám je důležitá zejména u rodinných domů, bytových domů a firemních objektů. Vlaštovky si často staví hnízda pod střechami nebo na fasádách, což může vést ke znečištění trusem a poškození omítky. Jedním...
Jak se zbavit vlhkosti ve zdi
Jak se zbavit vlhkosti ve zdi Jak se zbavit vlhkosti ve zdi je častá otázka majitelů domů i bytů. Vlhkost ve zdivu může způsobovat nejen estetické problémy, ale i vážné poškození konstrukce a vznik plísní nebo škůdců. Správné řešení závisí na odhalení...
Štípance v zimě
Štípance v zimě Štípance v zimě, často vyhledávané také jako stipance v zime, mohou být překvapivým problémem. Mnoho lidí si myslí, že hmyz se v zimním období nevyskytuje, ale opak je pravdou – některé druhy škůdců jsou aktivní po celý rok, zejména...
Ornitóza
Ornitóza Ornitóza, často vyhledávaná také jako ornitoza, je infekční onemocnění přenosné ze zvířat na člověka. Nejčastěji se přenáší z ptáků, zejména z holubů, papoušků nebo drůbeže. Toto onemocnění je způsobeno bakterií Chlamydia psittaci a může mít...
Zábrany proti jiřičkám
Zábrany proti jiřičkám Zábrany proti jiřičkám slouží k ochraně fasád, balkonů a dalších částí budov před hnízděním těchto ptáků. Jiřičky si často staví hnízda pod střechami, na římsách nebo v rozích domů, což vede ke znečištění trusem a poškození...
S čím vším vám můžeme pomoci?
606 366 287
DDD, tedy Dezinsekce, Dezinfekce a Deratizace. Mimo deratizace myší vám pomůžeme i s dalšími škůdci. Například úklid půdy a balkónu, dezinfekce a instalace sítí proti holubům.
Máte-li jakékoli dotazy nebo si přejete získat cenovou nabídku, kontaktujte nás e-mailem nebo telefonicky kliknutím na červené tlačítko.
Rádi vám pomůžeme.